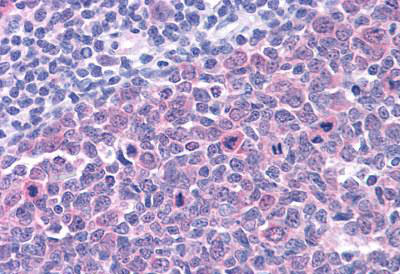
product-image-AAA51910_IHC11.jpg

Transcription activator BRG1 Recombinant Protein | SMARCA4 recombinant protein
Recombinant Human Transcription activator BRG1
Gene Names
SMARCA4; BRG1; SNF2; SWI2; MRD16; RTPS2; BAF190; SNF2L4; SNF2LB; hSNF2b; BAF190A
Purity
Greater or equal to 85% purity as determined by SDS-PAGE.
Synonyms
Transcription activator BRG1; N/A; Recombinant Human Transcription activator BRG1; SMARCA4 recombinant protein
Host
E Coli or Yeast or Baculovirus or Mammalian Cell
Specificity
Colocalizes with ZEB1 in E-cadherin-negative cells from established lines, and stroma of normal colon as well as in de-differentiated epithelial cells at the invasion front of colorectal carcinomas (at protein level).
Purity/Purification
Greater or equal to 85% purity as determined by SDS-PAGE.
Form/Format
Lyophilized or liquid (Format to be determined during the manufacturing process)
Sequence Positions
808-1092aa; Partial
Sequence
IIVPLSTLSNWAYEFDKWAPSVVKVSYKGSPAARRAFVPQLRSGKFNVLLTTYEYIIKDKHILAKIRWKYMIVDEGHRMKNHHCKLTQVLNTHYVAPRRLLLTGTPLQNKLPELWALLNFLLPTIFKSCSTFEQWFNAPFAMTGEKVDLNEEETILIIRRLHKVLRPFLLRRLKKEVEAQLPEKVEYVIKCDMSALQRVLYRHMQAKGVLLTDGSEKDKKGKGGTKTLMNTIMQLRKICNHPYMFQHIEESFSEHLGFTGGIVQGLDLYRASGKFELLDRILPKL
Subcellular Location
Nucleus
Protein Families
SNF2/RAD54 helicase family
Preparation and Storage
The shelf life is related to many factors, storage state, buffer ingredients, storage temperature and the stability of the protein itself. Generally, the shelf life of liquid form is 6 months at -20 degree C/-80 degree C. The shelf life of lyophilized form is 12 months at -20 degree C/-80 degree C.
Repeated freezing and thawing is not recommended. Store working aliquots at 4 degree C for up to one week.
Repeated freezing and thawing is not recommended. Store working aliquots at 4 degree C for up to one week.
Related Product Information for SMARCA4 recombinant protein
Transcriptional coactivator cooperating with nuclear hormone receptors to potentiate transcriptional activation. Component of the CREST-BRG1 complex, a multiprotein complex that regulates promoter activation by orchestrating a calcium-dependent release of a repressor complex and a recruitment of an activator complex. In resting neurons, transcription of the c-FOS promoter is inhibited by BRG1-dependent recruitment of a phospho-RB1-HDAC repressor complex. Upon calcium influx, RB1 is dephosphorylated by calcineurin, which leads to release of the repressor complex. At the same time, there is increased recruitment of CREBBP to the promoter by a CREST-dependent mechanism, which leads to transcriptional activation. The CREST-BRG1 complex also binds to the NR2B promoter, and activity-dependent induction of NR2B expression involves a release of HDAC1 and recruitment of CREBBP. Belongs to the neural progenitors-specific chromatin remodeling complex (npBAF complex) and the neuron-specific chromatin remodeling complex (nBAF complex). During neural development a switch from a stem/progenitor to a post-mitotic chromatin remodeling mechanism occurs as neurons exit the cell cycle and become committed to their adult state. The transition from proliferating neural stem/progenitor cells to post-mitotic neurons requires a switch in subunit composition of the npBAF and nBAF complexes. As neural progenitors exit mitosis and differentiate into neurons, npBAF complexes which contain ACTL6A/BAF53A and PHF10/BAF45A, are exchanged for homologous alternative ACTL6B/BAF53B and DPF1/BAF45B or DPF3/BAF45C subunits in neuron-specific complexes (nBAF). The npBAF complex is essential for the self-renewal/proliferative capacity of the multipotent neural stem cells. The nBAF complex along with CREST plays a role regulating the activity of genes essential for dendrite growth. SMARCA4/BAF190A may promote neural stem cell self-renewal/proliferation by enhancing Notch-dependent proliferative signals, while concurrently making the neural stem cell insensitive to SHH-dependent differentiating cues (By similarity). Acts as a corepressor of ZEB1 to regulate E-cadherin transcription and is required for induction of epithelial-mesenchymal transition (EMT) by ZEB1.
Product Categories/Family for SMARCA4 recombinant protein
NCBI and Uniprot Product Information
NCBI GI #
NCBI GeneID
NCBI Accession #
NCBI GenBank Nucleotide #
Molecular Weight
37.1 kDa
NCBI Official Full Name
transcription activator BRG1 isoform B
NCBI Official Synonym Full Names
SWI/SNF related, matrix associated, actin dependent regulator of chromatin, subfamily a, member 4
NCBI Official Symbol
SMARCA4
NCBI Official Synonym Symbols
BRG1; SNF2; SWI2; MRD16; RTPS2; BAF190; SNF2L4; SNF2LB; hSNF2b; BAF190A
NCBI Protein Information
transcription activator BRG1
UniProt Protein Name
Transcription activator BRG1
UniProt Gene Name
SMARCA4
UniProt Synonym Gene Names
BAF190A; BRG1; SNF2B; SNF2L4; BAF190A
UniProt Entry Name
SMCA4_HUMAN
Customer Reviews
Loading reviews...
Share Your Experience
Similar Products
Product Notes
The SMARCA4 smarca4 (Catalog #AAA113616) is a Recombinant Protein produced from E Coli or Yeast or Baculovirus or Mammalian Cell and is intended for research purposes only. The product is available for immediate purchase. The immunogen sequence is 808-1092aa; Partial. The amino acid sequence is listed below: IIVPLSTLSN WAYEFDKWAP SVVKVSYKGS PAARRAFVPQ LRSGKFNVLL TTYEYIIKDK HILAKIRWKY MIVDEGHRMK NHHCKLTQVL NTHYVAPRRL LLTGTPLQNK LPELWALLNF LLPTIFKSCS TFEQWFNAPF AMTGEKVDLN EEETILIIRR LHKVLRPFLL RRLKKEVEAQ LPEKVEYVIK CDMSALQRVL YRHMQAKGVL LTDGSEKDKK GKGGTKTLMN TIMQLRKICN HPYMFQHIEE SFSEHLGFTG GIVQGLDLYR ASGKFELLDR ILPKL. It is sometimes possible for the material contained within the vial of "Transcription activator BRG1, Recombinant Protein" to become dispersed throughout the inside of the vial, particularly around the seal of said vial, during shipment and storage. We always suggest centrifuging these vials to consolidate all of the liquid away from the lid and to the bottom of the vial prior to opening. Please be advised that certain products may require dry ice for shipping and that, if this is the case, an additional dry ice fee may also be required.Precautions
All products in the AAA Biotech catalog are strictly for research-use only, and are absolutely not suitable for use in any sort of medical, therapeutic, prophylactic, in-vivo, or diagnostic capacity. By purchasing a product from AAA Biotech, you are explicitly certifying that said products will be properly tested and used in line with industry standard. AAA Biotech and its authorized distribution partners reserve the right to refuse to fulfill any order if we have any indication that a purchaser may be intending to use a product outside of our accepted criteria.Disclaimer
Though we do strive to guarantee the information represented in this datasheet, AAA Biotech cannot be held responsible for any oversights or imprecisions. AAA Biotech reserves the right to adjust any aspect of this datasheet at any time and without notice. It is the responsibility of the customer to inform AAA Biotech of any product performance issues observed or experienced within 30 days of receipt of said product. To see additional details on this or any of our other policies, please see our Terms & Conditions page.Item has been added to Shopping Cart
If you are ready to order, navigate to Shopping Cart and get ready to checkout.